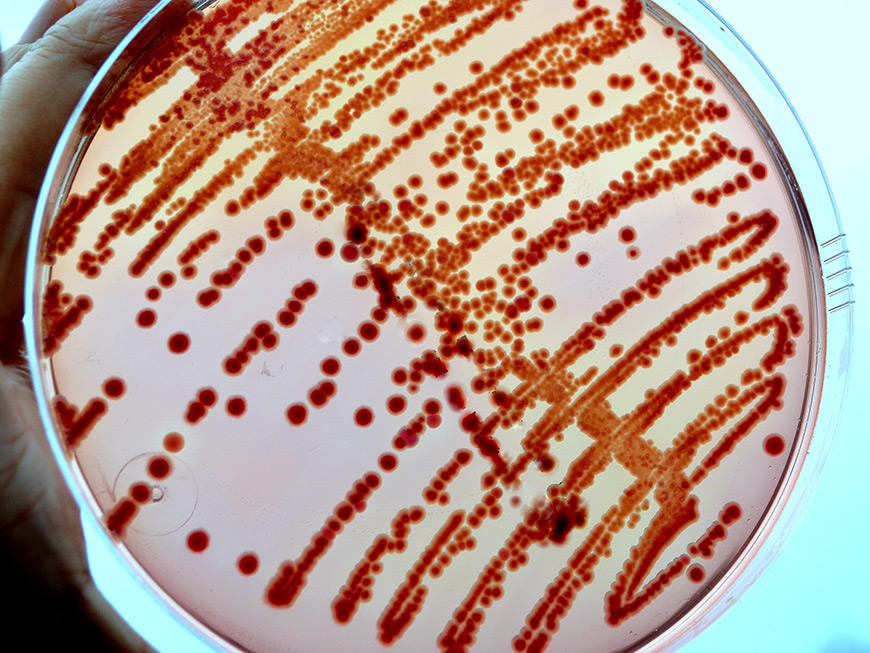
microbiota

Projects
The International Microbiome Centre (IMC) at the University of Calgary is a translational research centre, designed to investigate the microbiome of plants, animals and the physical environment.

Balancing the body’s bacteria
Dr. Tom Louie, MD
Clostidium difficile is painful hospital infection that causes severe fever and prolonged diarrhea, which can lead to blood poisoning and death. Treatment has greatly improved thanks to Dr. Louie's groundbreaking work. He's a pioneer in the use of fecal transplants to put the body’s bacteria back into balance to cure the infection. He also created a pill treatment that eliminates the uncomfortable process of transplanting feces into intestines.
Advancing knowledge of the body’s bacterial balance can lead to great changes. For example, clinical trials are proving that a probiotic pill given to at-risk adults admitted into the hospital can prevent nearly 75 percent from contracting C. difficile. Our study of the microbiome in Calgary patients taking probiotics is helping advance our knowledge of how to balance bacteria in the body.
Alberta BLOOM study: Begin a life of health with observation and optimization of the microbiome
Marie Claire Arrieta, PhD and Laura Sycuro, PhD
The microbiome is inherited largely from our mother at birth and in our first years of life, forming an integral part of our unique physiological identity.
Recent studies have found that changes in the microbiome very early in life can herald the onset of disease years later, but more research is needed. New data also suggests the maternal microbiome could have significant effect on a child’s health. Understanding how the maternal and early life microbiome interacts with our human genetic background and environment is one of the greatest frontiers in modern medicine.
The BLOOM study looks at the microbiomes of 1,000 babies born in Alberta. We'll examine how the microbiome changes from the womb, through birth, and through the use of antibiotics in the first five years of life.
This study aims to trace the microbial links between mothers and their neonates in pregnancy, birth, and up to one year postpartum. The broad goals of the study: Molecular surveys of the microbiome and host to identify biomarkers, along with their mechanistic underpinnings. This will provide diagnostic value or predictive information of long-term health outcomes.


Changing the course of autism in newly diagnosed cases by FMT. A study of the possible microbial links with neurodevelopmental disorders.
Tom Louie
Late-onset autism has been increasingly diagnosed over the past two decades. Genetic susceptibility to autism has been extensively examined without yielding insight as to causation of autism. A microbial ecologic cause, either related to dysbiotic host flora or occult infection by neurotoxic intestinal microbes was postulated based on a common pattern of antibiotic exposure and syndrome onset.
In 2000 Dr. Sidney Finegold published a case series of suggesting a possible link with clostridial organism infection. In the past 5 years, incidental case referrals for fecal transplantation has shown that prior treatment with vancomycin ameliorates symptoms in some patients, and fecal transplantation averts the regression or partially ameliorates clinical findings for variable durations in children that are between 3-8 years age. Serial fecal sampling prior to antibiotic treatment, after attempted ablation of the intestinal microbiota with multiple antibiotic treatment with nitazoxanide, vancomycin, norfloxacin and nystatin (the latter 2 to prevent overgrowth of gamma proteobacteria and fungi, respectively), and after fecal transplantation, with quantitative total anaerobic cultures to recover the most numerically dominant clones and to subject these clones for sequencing identity suggests certain clostridial organisms are present in association with neurocognitive dysfunction.
It is proposed to study a cohort of newly diagnosed children with late onset autism aged 3-5 years of ages in an randomized placebo controlled clinical trial and to follow clinical and microbial end points in a collaborative study.

Ecology of the human early life microbiome
Marie Claire Arrieta, PhD
We know we get colonized with trillions of microbes as soon as we're born, but how does this happen? Is there an evolutionarily conserved sequence of events? And if so, which ecological process(es) drive this? How does our modern lifestyle influence this pattern of colonization during early life? These are the questions we're trying to answer using birth cohort studies in industrialized and non-industrialized countries.
Exploring oil sands could be the key to developing new bug-killing drugs
Joe Harrison, PhD
Recent reports suggest antibiotic-resistant bacteria could kill 10 million people per year by 2050 if left unchecked. With a cost of $100 trillion to the world’s economy. Assistant professor Joe Harrison and his colleagues believe the microbiome of Alberta’s oil sands may hold the key to a solution.
The deep biosphere of the oil sands contains molecules that can break up bacterial biofilms. Biofilms are groups of harmful microorganisms surrounded by a layer of slime that causes infection. The research team uses chemistry to identify promising compounds that may lead to clinical traits to combat infections in humans.
The discovery of new antibiotics from this untapped resource may save the lives of those suffering from deadly bacterial infections resistant to known antibiotics. It may also hold clues to cures for other diseases. And it has the potential to stimulate the natural biological clean-up of things like oil spills on our oceans.

How does the interaction between intestinal microbiota and the immune system affect health and diseases?
Markus Geuking, PhD
The microbiota has been shown to be implicated in a range of immune-mediated disorders including inflammatory bowel disease, autoimmunity, and allergy. Therefore, altering the composition or function of the microbiota is a promising therapeutic approach to modulate immune responses involved in disease. Because T helper cells are involved in both immune adaptations to colonization and pathologic processes in disease, the lab focuses on the interaction of the microbiota with T helper cells.
The team uses germ free mice in combination with genetically modified commensal species to interrogate whether and how the microbiota can modulate T helper cell responses. This allows for carefully controlled and defined experiments to study how the microbiota modulates T helper cell response, but also how, in return, T helper cell responses directed at the microbiota impact on the microbiota at the level of transcriptional or metabolic activity and microbiota composition.
These are important parameters that need to be defined to be able to rationally design therapies that involve use of the microbiota as a tool to therapeutically modulate immune responses in disease.
This project develops genetically modified microbes as tools to study antigen-specific T helper cell responses in gnotobiotic situations with precisely defined species composition of the microbiota. This allows the use of state-of-the-art technologies including intravital microscopy, next generation transcriptional profiling of individual sorted species, and immunophenotyping using flow and mass cytometry to be used as readouts.
It's not just bacteria, is it?
Marie Claire Arrieta, PhD
We're colonized with a complex mix of bacteria, fungi, protozoans, helminths and viruses, yet the majority of microbiome studies worldwide only include bacteria. What influence do non-bacterial microbes have in the gut microbiome? How do these microbes affect bacterial communities? How to they interact with our immune system? We're applying ecological theory concepts to explore the relationships between microbial eukaryotes and prokaryotes, using bioinformatic and mouse model strategies.


The early-life microbiome in asthma development
Marie Claire Arrieta, PhD
Asthma is the chronic disease that affects most children around the world. Its incidence continues to increase rapidly, and cases are becoming more severe. Research from Drs. Arrieta, Finlay and collaborators has shown that changes in the gut microbiome very in early in life can increase a baby's risk to develop asthma. Our lab is interested in finding more bacteria and fungi involved in this association, exploring the immune mechanisms behind it, and finding ways to correct it. We're answering these questions using data from our human studies and modelling it in mouse models of airway inflammation.
The immune system and the microbiome
Paul Kubes, PhD
Imaging is used to visualize both the microbiome and the immune system — or immunobiome — and investigate how these two systems interact. His latest work is examining how the gut microbiome develops in the presence and absence on antibiotics in neonate. And how the lung microbiome differs from other microbiomes to directly affect the lung immune system. In both cases, imaging is used to visualize the biology of immune cells.

What is the connection between the microbiome and your diet?
Raylene Reimer, PhD
Reimer’s microbiome project focuses on the influence of diet on our microbiome. And how we can use dietary interventions to improve gut microbiota composition and function in chronic disease. Her lab has pioneered research in the use of prebiotics to prevent and treat metabolic diseases.
In rodents The lab is looking at the role of gut microbiota in triggering insulin resistance and obesity related to early life exposure to antibiotics and artificial sweeteners.
In humans The lab is looking at whether prebiotics can improve gut microbiota and disease management in non-alcoholic fatty liver disease in adults and obsessive-compulsive disorder in youth.
She's also collaborating with other researchers at the University of Calgary. They're examining the role of gut microbiota and dietary intervention in preventing and/or treating osteoarthritis and weight gain, as well as metabolic syndrome associated with antipsychotic medication in children and youth.


What is the microbiome’s role in immunity and disease?
Kathy McCoy, PhD
Dr. McCoy leads research in the 10,000-square-foot facility germ-free facility to understand the interaction between the microbiome and the immune system to prevent and treat illness. The facility houses thousands of mice under germ-free conditions. This lets researchers transplant specific microbiomes into germ-free animals. When we pair this with incredible imaging capacity, researchers can observe the behaviour of our microbiome in an environment free from other bacterial or viral contaminants. And how their introduction or removal shapes human health. That allows us to develop more personalized therapies, treatments and preventative measures for people living with chronic diseases.